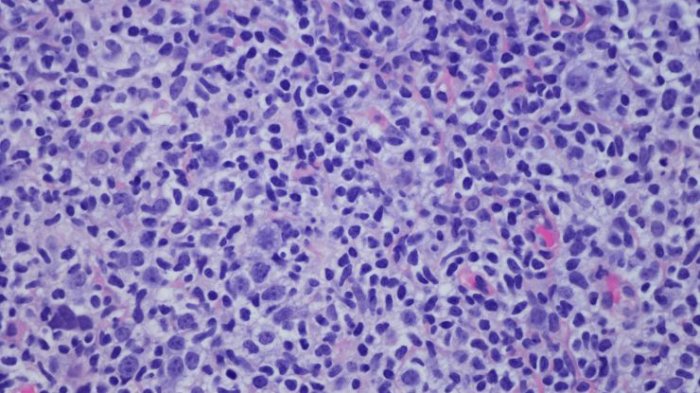
Prometedora vacuna contra el cáncer logra curar el linfoma de 3 pacientes

Minuto a minuto
Sismo despierta a los habitantes de la zona norte: Revisa su magnitud y epicentro
Bus que transportaba a banda Zúmbale Primo sufrió un accidente en la Ruta 5 Sur
Yacarés en Playa Cavancha: Video abrió debate sobre cautiverio de fauna exótica
Crece debate por ayuda desde Chile a Cuba: Oposición citará a Van Klaveren a declarar al Senado
Presidente Boric abogó por sala cuna universal y el fin al CAE en último consejo de gabinete